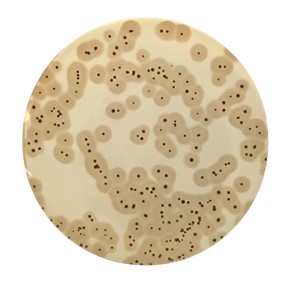

NGUYÊN TẮC:
Môi trường cơ bản được làm theo công thức đặc biệt để đảm bảo tốc độ tăng trưởng của Staphylococcus aureus trong 22 giờ. Việc tối ưu hóa các hệ thống chọn lọc cải thiện sự ức chế của hệ thực vật thứ cấp thường được quan sát trên Baird-Parker agar.
Chất bổ sung EASY Staph® tương ứng với Fibrinogen huyết tương thỏ. Các thành phần được điều chỉnh để có được một sự phát triển của quầng sáng của sợi huyết trong 22 giờ.
Huyết tương thỏ đã được lựa chọn vì đặc tích đặc biệt của nó đối với Staphylococcus (+) coagulase và khả năng đông tụ nhanh bởi hình thành staphylo thrombin từ prothrombin.
Staphylo Thrombin hoạt động bằng cách cắt fibrinopeptides A và B của fibrinogen, từ đó bắt đầu quá trình trùng hợp finbrin dẫn tới kết quả là sự xuất hiện của quầng sáng sợi huyết xung quanh các khuẩn lạc.
Chất ức chế trypsin của đậu nành ngăn ngừa phân hủy fibrin.
Quy trinh đơn giản:
Pha loãng x(g) mẫu vào 9x (ml) dung dịch pha loãng => Trải trang 0,1ml mẫu hoặc dùng phương pháp đổ đĩa 1ml mẫu vào môi trường EASY Staph. Ủ 37 °C trong 24h.
Đọc kết quả mà không cần khẳng định lại. Khuẩn lạc đặc trưng tâm đen, có quầng đục.
Có nhiều mã sản phẩm với các quy cách đóng gói khác nhau: BK216HA; BK216GC; BS09008; BS09708; BM18708; BM19008; BT01208; BT01308

English